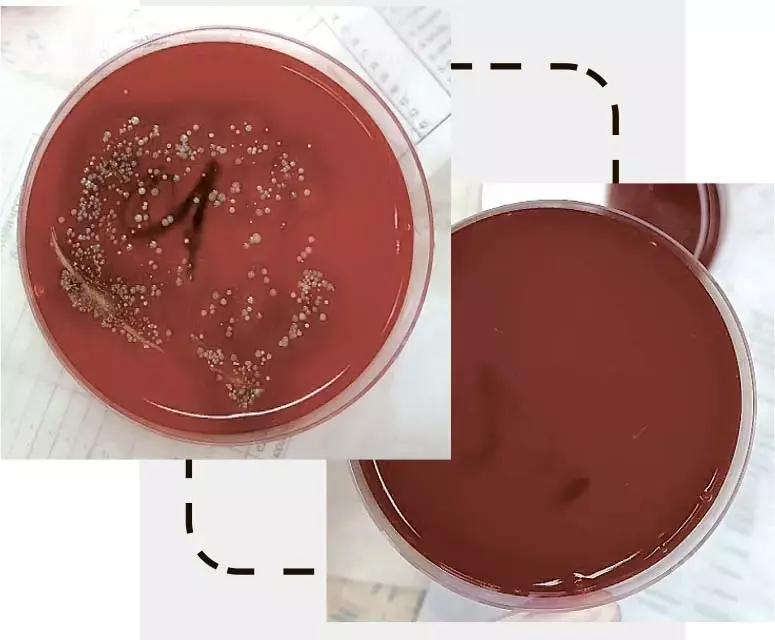

Инфекции, связанные с оказанием медицинской помощи (ИСМП), возникают во всем мире и являются одними из главных причин смерти среди госпитализированных пациентов. Гигиена рук — главная составляющая в профилактике таких инфекций.
 Илона ЛихорадВ соответствии с данными ВОЗ, соблюдение правил гигиены рук может снизить риск распространения инфекций на 70 %. В условиях больницы, где пациенты могут быть особенно уязвимы, соблюдение этих норм становится критически важным.
Илона ЛихорадВ соответствии с данными ВОЗ, соблюдение правил гигиены рук может снизить риск распространения инфекций на 70 %. В условиях больницы, где пациенты могут быть особенно уязвимы, соблюдение этих норм становится критически важным.
Почему не соблюдается гигиена?
Гигиена рук медицинского персонала является одной из важнейших мер профилактики передачи госпитальных инфекций в лечебном учреждении и при этом легко выполняемой процедурой (см. рис. 1).
Рисунок 1. Результаты проведенных смывов с рук медицинского персонала методом отпечатков в рамках инфекционного контроля. слева — смывы, взятые до обработки рук антисептиком, справа — после обработки. Методика позволяет визуально оценить качество проведенной гигиенической обработки рук медицинским персоналом, а также выявить имеющиеся нарушения в технике данной процедуры.
Рисунок 1. Результаты проведенных смывов с рук медицинского персонала методом отпечатков в рамках инфекционного контроля. слева — смывы, взятые до обработки рук антисептиком, справа — после обработки. Методика позволяет визуально оценить качество проведенной гигиенической обработки рук медицинским персоналом, а также выявить имеющиеся нарушения в технике данной процедуры.
Основные причины:
- отсутствие понимания важности этой процедуры, скептическое отношение к гигиене рук, сомнения в эффективности и негативный пример более старших коллег;
- недостаток времени, необходимого для обработки рук;
- отсутствие необходимых условий для обработки рук (нехватка мыла, салфеток, полотенец и т. д.);
- нарушение техники выполнения гигиены рук;
- постоянное ношение перчаток (убежденность, что перчатки избавляют от необходимости соблюдения гигиены рук);
- дерматит, вызванный частым и неадекватным мытьем рук;
- недостаток знания руководств, протоколов.
Методика деконтаминации
На сегодняшний момент существует единственная методика деконтаминации кожи рук, зарегистрированная как «Европейский стандарт обработки рук — EN-1500». Это поуровневая методика обработки рук (с гигиенического до хирургического уровня).
Уровни деконтаминации рук:
1. Гигиеническое мытье (удаление грязи и транзиторной микрофлоры, попавшей на кожу рук персонала в результате контакта с пациентами или объектами окружающей среды):
- в начале и в конце рабочей смены;
- перед гигиенической антисептикой кожи рук (если руки загрязнены);
- перед выполнением хирургической антисептики рук;
- после снятия перчаток;
Важно! Перчатки во время выполнения манипуляций не рекомендуется обрабатывать антисептическими и дезинфицирующими средствами, так как это отрицательно влияет на их герметичность и может привести к усилению проницаемости!
- перед приготовлением, раздачей и приемом пищи;
- после посещения туалета.
2. Гигиеническая антисептика (удаление или уничтожение транзиторной микрофлоры):
- до и после контакта с пациентом;
- перед надеванием перчаток (если явное загрязнение рук отсутствует) и после снятия перчаток;
- перед чистой/асептической процедурой;
- после контакта с биологическими жидкостями;
- после контакта с объектами внешней среды;
- при переходе от контаминированных участков тела пациента к чистым (при выполнении манипуляций по уходу за пациентом).
 Рисунок 2. Правила гигиены рук.При выполнении техники гигиенической антисептики рук наиболее тщательно обрабатываются так называемые критические участки: большие пальцы и кончики пальцев, межпальцевые зоны, ногти, околоногтевые валики и подногтевые зоны (см. рис. 2).
Рисунок 2. Правила гигиены рук.При выполнении техники гигиенической антисептики рук наиболее тщательно обрабатываются так называемые критические участки: большие пальцы и кончики пальцев, межпальцевые зоны, ногти, околоногтевые валики и подногтевые зоны (см. рис. 2).
3. Хирургическая антисептика (удаление или уничтожение транзиторной микрофлоры и значительное снижение численности резидентной флоры). Проводят члены хирургической бригады перед выполнением манипуляций, связанных с контактом с внутренними стерильными средами организма.
Простые меры по выбору препаратов и профилактике кожных реакций помогут повысить мотивацию медработников и тем самым снизить распространение нозокомиальных инфекций.

